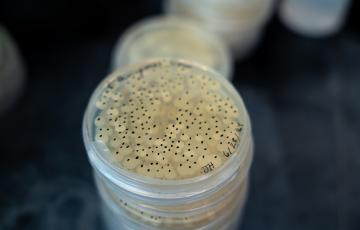
IMET 1

Land-based Salmon Aquaculture Conference Advances Expert Collaborations

Finfish aquaculture specialists, from both academia and industry gathered in Baltimore from October 14 through 16 for the Sustainable Aquaculture Systems Supporting Atlantic Salmon (SAS²) conference. Hosted by the Institute of Marine and Environmental Technology (IMET) the meeting pulled together to 80 leading figures, for panel discussions, presentations and facility tours all aimed at pushing land‑based salmon aquaculture forward.
"The SAS² project is centered on forging partnerships and collaborations, between academia and industry "
Dr. Yonathan Zohar, the projects director remarked. "Our aim is to make land‑based Atlantic salmon farming both more environmentally responsible and more efficient while also cutting costs."
Backed by a $10 million USDA grant SAS² is grappling with the challenges of recirculating aquaculture systems (RAS) technology while simultaneously nurturing innovation, education and workforce development. The conference brought together keynote speakers, from the United States and overseas showcased research updates and sparked discussions, on product quality, feed sustainability and waste management.Now as it marks its year SAS² has managed to marshal of $11 million, in additional funding put out 23 scientific papers and pull in thousands of students and stakeholders from, across the nation.
Learn more about SAS² and it's mission to strengthen U.S. Aquaculture at salmononland.org.
Our Mission
IMET's mission is to develop innovative approaches to protect and restore coastal marine systems and their watersheds, sustainably use resources in ways to benefit human well-being, and to integrate research excellence with education, training and economic development.
Entrepreneurship Programs
The Institute of Marine and Environmental Technology houses a business incubator and entrepreneurship program dedicated to assisting early stage science and science support companies. Click below to learn more about the marine, environmental, biotech, and human health startups that have benefited from these programs.